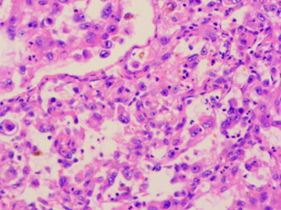
Επιθηλιοειδή κακοήθη κύτταρα, με εμφανή κυτταρική ατυπία και μιτωτικές φιγούρες (Ευγενική παραχώρηση Dr. V. Penopoulos)

ΠΡΩΤΟΠΑΘΕΣ ΟΠΙΣΘΟΠΕΡΙΤΟΝΑΙΚΟ ΑΓΓΕΙΟΣΑΡΚΩΜΑ
Primary Retroperitoneal Angiosarcoma
Περίληψη
Primary retroperitoneal sarcomas are rare mesenchymal tumors, with liposarcoma being most common and angiosarcoma an exceptionally uncommon and highly aggressive variant with poor prognosis. We report a 68-year-old patient admitted to a regional hospital with acute abdominal pain, respiratory distress, and hypotension. After resuscitation, abdominal CT revealed a large (10 x 6.8 cm; craniocaudal 16.4 cm) multilobulated, low-density retroperitoneal mass in the left iliac fossa, extending from the lower pole of the left kidney to the coccyx, posterior to the external iliac vessels. Thoracic staging was negative. Radical surgical resection was performed, and histopathology with immunohistochemistry confirmed primary retroperitoneal angiosarcoma. Adjuvant therapy was planned in the multidisciplinary setting. This case underscores the aggressive behavior of retroperitoneal angiosarcoma and emphasizes the importance of early diagnosis and radical surgical resection for any chance of improved survival.
Εισαγωγή
ΠΡΩΤΟΠΑΘΕΣ ΟΠΙΣΘΟΠΕΡΙΤΟΝΑΙΚΟ ΑΓΓΕΙΟΣΑΡΚΩΜΑ . ΑΝΑΚΟΙΝΩΣΗ ΜΟΝΑΔΙΚΗΣ ΠΕΡΙΠΤΩΣΗΣ ΚΑΙ ΑΝΑΣΚΟΠΗΣΗ ΤΗΣ ΒΙΒΛΙΟΓΡΑΦΙΑΣ . ΒΑΣΙΛΕΙΟΣ ΠΕΝΟΠΟΥΛΟΣ – ΓΕΝΙΚΟΣ ΧΕΙΡΟΥΡΓΟΣ . ΔΕΣΠΟΙΝΑ ΣΓΟΥΡΙΔΗ – ΓΕΝΙΚΟΣ ΧΕΙΡΟΥΡΓΟΣ . Β’ ΧΕΙΡΟΥΡΓΙΚΗ ΚΛΙΝΙΚΗ – Γ . Ν . Θ . «Γ . ΠΑΠΑΝΙΚΟΛΑΟΥ» .
Το πρωτοπαθές οπισθοπεριτοναικό σάρκωμα , αποτελεί ένα κακοήθη όγκο , εξορμώμενο από τα μεσεγχυματικά κύτταρα του οπισθοπεριτοναικού χώρου .Οι όγκοι αυτοί είναι σπάνιοι και εμφανίζονται με συχνότητα 0.0027% . Μεταξύ των διαφόρων τύπων , το λιποσάρκωμα παρουσιάζεται συχνότερα , με τους κακοήθεις όγκους των θηκών των περιφερικών νεύρων και τα αγγειοσαρκώματα να συναντώνται σπανιότερα . Το αγγειοσάρκωμα επιδεικνύει υψηλό βαθμό κακοήθειας και ως εκ τούτου η πρόγνωση του είναι πενιχρή . Η έγκαιρη διάγνωση και η δέουσα θεραπευτική αντιμετώπιση έχουν επίπτωση στην επιβίωση των ασθενών αυτών . Η παρούσα ανακοίνωση , περιγράφει ένα πρωτοπαθές οπισθοπεριτοναικό σάρκωμα σε ένα μεσήλικα ασθενή .
Ένας 68χρονος ασθενής , εισήχθη σε επαρχιακό νοσοκομείο , παραπονούμενος για οξύ κοιλιακό άλγος , δυσχέρεια αναπνοής και πτώση της αρτηριακής πίεσης. Μετά την αρχική αναζωογόνηση , έγινε αξονική τομογραφία κοιλίας , η οποία ανέδειξε την παρουσία , ευμεγέθους , πολυλοβωτής , χαμηλής πυκνότητας , εξεργασίας μαλακών ιστών , στην περιοχή του αριστερού λαγονίου βόθρου , ενδεικτικών διαστάσεων 10 Χ 6.8 εκ . που ανέρχονταν προς τα επάνω , μέχρι τον κάτω πόλο του αριστερού νεφρού , ενώ κατέρχονταν όπισθεν των έξω λαγονίων αγγείων , μέχρι το ύψος των κοκκυγικών σπονδύλων ( ενδεικτική κεφαλουραία διάμετρος 16.4 εκ . ) . Τα υπόλοιπα όργανα της κοιλίας ήταν φυσιολογικά , όπως φυσιολογική ήταν και η εκτελεσθείσα σε 2ο χρόνο αξονική τομογραφία θώρακος , χωρίς την ανάδειξη μεταστατικών εστιών στο ήπαρ ή στους πνεύμονες . Μετά την σταθεροποίηση του , ο ασθενής ανέφερε ότι βίωνε ένα αμβλύ άλγος στην αριστερή οσφύ , τους τελευταίους 2 μήνες , το οποίο απέδιδε στην δυσκοιλιότητα . Από το ατομικό και οικογενειακό ιατρικό ιστορικό , δεν υπήρξε κάτι το άξιο λόγου . Κατά την κλινική εξέταση , διαπιστώθηκε εκσεσημασμένη διάταση κοιλίας , με σύσπαση αριστερά χωρίς περιτοναισμό και βύθιους εντερικούς ήχους . Υπήρξε αδυναμία ψηλάφησης μαζών . Η Hb ήταν 8 gr , οπότε και μεταγγίστηκε με δύο μονάδες ερυθρών κυττάρων . Ο χρόνος προθρομβίνης ήταν φυσιολογικός , όπως ήταν οι ηπατικές δοκιμασίες και οι λοιπές βιοχημικές εξετάσεις . Τα επίπεδα των κατεχολαμινών , της κορτιζόλης και της αλδοστερόνης ήταν εντός των φυσιολογικών ορίων . Την επόμενη ημέρα , με απαίτηση της οικογένειας του , ο ασθενής διακομίστηκε στην κλινική μας για περεταίρω αντιμετώπιση . Εικόνα 1 . CT Scan Κοιλίας . Τεράστια οπισθοπεριτοναική μάζα αριστερά . ( Αρχείο κος Β . Πενόπουλος ) . Αφού λάβαμε υπ’ όψιν μας , το αρνητικό για σοβαρές παθήσεις ιατρικό ιστορικό του ασθενούς , την παρουσία ενός εξαιρέσιμου οπισθοπεριτοναικού όγκου ο οποίος αιμορράγησε ( πτώση Α . Π . και Hb ) , την απουσία εγκλωβισμού / διήθησης κρίσιμων αγγείων από τον όγκο , την απουσία μεταστάσεων , την επαπειλούμενη απόφραξη του αριστερού ημικόλου και την ανάγκη μιας αξιόπιστης διάγνωσης , αποφασίσαμε να προχωρήσουμε στην εκτέλεση ερευνητικής λαπαροτομίας . Μετά την διάνοιξη της κοιλίας , διαπιστώσαμε την παρουσία αιμοπεριτοναίου , το οποίο προφανώς προεκλήθη από την ρήξη και την αιμορραγία του αγγειοβριθούς οπισθοπεριτοναικού όγκου . Μετά την αφαίρεση περίπου 1 λίτρου αίματος και θρόμβων , αποκαλύφθηκε μία εύθρυπτη , σκουρόχρωμη μάζα , διαστάσεων 10.5 Χ 7.2 εκ . , κάτωθεν του κάτω πόλου του αριστερού νεφρού , με ασαφή όρια , η οποία ήταν συμπεφυμένη στερεά με τον αριστερό ψοίτη μύ . Τα περιφερικά αγγειακά στελέχη ήταν ελαφρώς διατεταμένα ως εκ της πιέσεως της μάζας αλλά δεν παρατηρήθηκαν διακυμάνσεις της αρτηριακής πίεσης κατά την διάρκεια των χειρισμών του όγκου . Με προσεκτικούς χειρισμούς και παρά την αιμορραγική διάθεση του ασθενούς , κατέστη δυνατή η πλήρης αφαίρεση του όγκου χωρίς μείζονα αιμορραγία , συμπεριλαμβανομένων των τμημάτων όπισθεν των έξω λαγονίων αγγείων , en bloc μετά του κατιόντος κόλου και του σιγμοειδούς τα οποία θεωρήθηκαν διηθημένα από τον όγκο κατά συνέχεια ιστού - εγχείρηση κατά Hartmann . Εικόνα 2 . Αγγειοσάρκωμα . Διατομή παρασκευάσματος . ( Αρχείο κος Β . Πενόπουλος ) . Εικόνα 3 . Λεπτομέρεια εσωτερικού αγγειοσαρκώματος . ( Αρχείο κος Β . Πενόπουλος ) . Εικόνα 4 . Συρρικνωμένο κατιόν και σιγμοειδές κόλον . Κόκκινα βέλη . Διήθηση του παχέος εντέρου κατά συνέχεια ιστού . ( Αρχείο κος Β . Πενόπουλος ) . Εικόνα 5 . «Θυγατρικοί» όγκοι προσκολλημένοι προιερά . ( Αρχείο κος Β . Πενόπουλος ) . Η ιστοπαθολογική εξέταση , αποκάλυψε πως η οπισθοπεριτοναική μάζα , ήταν ένας κακοήθης όγκος , με ιστική νέκρωση στο εσωτερικό της νεοπλασίας . Τα καρκινικά κύτταρα ήταν επιθηλιοειδή κύτταρα με προφανή κυτταρική ατυπία και έντονη μιτωτική δραστηριότητα . Η ανοσοιστοχημική εξέταση , ανέδειξε θετική αντίδραση στην πανκυτοκερατίνη , βιμεντίνη και CD31 . Αντίθετα δεν υπήρξε αντίδραση σε διάφορους δείκτες , όπως το αντιγόνο της επιθηλιακής μεμβράνης , S100 , τον παράγοντα μεταγραφής SOX-10 , το μαύρο-45 του ανθρωπίνου μελανώματος , το melan-A , την ποδοπλανίνη , το CD117 , τον παράγοντα μεταγραφής-1 του θυρεοειδούς , την χρωμογρανίνη Α και την ακτίνη των λείων μυικών ινών . Τέλος , ο δείκτης του αντιγόνου Ki-67 , ήταν περίπου 50% . Εικόνα 6 . Επιθηλιοειδή καρκινικά κύτταρα , με προφανή κυτταρική ατυπία και μιτωτικές εικόνες . ( Αρχείο κος Β . Πενόπουλος ) . Εικόνα 7 . Ανοσοιστοχημική εξέταση-CD31 (+). ( Αρχείο κος Β . Πενόπουλος ) . Ο ασθενής είχε ομαλή μετεγχειρητική πορεία και εξήλθε του Νοσοκομείου μας 10 ημέρες αργότερα . Προ της εξόδου του , εκτιμήθηκε από ογκολόγο και προγραμματίστηκε να λάβει συμπληρωματική θεραπεία . Παρέμεινε ελεύθερος συμπτωμάτων , με καλή ποιότητα ζωής για μεγάλο χρονικό διάστημα . Απεβίωσε 18 μήνες αργότερα , μετά την εμφάνιση πολλαπλών μεταστάσεων στους πνεύμονες .
Παρουσίαση Περιστατικού
Το αγγειοσάρκωμα , είναι ένας επιθετικός κακοήθης όγκος των ενδοθηλιακών κυττάρων , που εξορμάται από λεμφαγγεία ή αιμοφόρα αγγεία και υπολογίζεται ότι αποτελεί περίπου το 1% όλων των σαρκωμάτων των μαλακών ιστών . Οι παθολογικές εκδηλώσεις του αγγειοσαρκώματος , διαφέρουν ανάλογα με τον βαθμό κακοήθειας των διαφόρων όγκων . Για παράδειγμα , ένα χαμηλής κακοήθειας αγγειοσάρκωμα , συχνά εμφανίζεται σαν μία μικρή , συμπαγής , εστία/βλάβη , με μικρό πληθυσμό κυττάρων και άφθονα διατιτραίνοντα αγγεία . Αντίθετα η παρουσίαση ενός υψηλής κακοήθειας αγγειοσαρκώματος , συχνά περιλαμβάνει κυτταροπλήθια , υψηλή μιτωτική δραστηριότητα και άτυπα κύτταρα . Το αγγειοσάρκωμα , μπορεί να εμφανιστεί σε οποιοδήποτε μέρος του σώματος , σε όλες τις ηλικίες , αν και συχνότερα παρουσιάζεται στους ηλικιωμένους – μέση ηλικία 60 – 71 έτη . Συχνότερα ανευρίσκεται στο δέρμα – 50% των περιπτώσεων – ενώ οπισθοπεριτοναικά συναντάται σε ποσοστό 10 – 15% . Η αιτιολογία εμφάνισης ενός αγγειοσαρκώματος δεν έχει αποσαφηνιστεί . Ως παράγοντες επικινδυνότητας θεωρεούνται , η έκθεση σε ακτινοβολία ή ακτινοθεραπεία , το χρόνιο λεμφοίδημα και η έκθεση σε χημικά , όπως το χλωριούχο βινύλιο . Ο ασθενής της περίπτωσης μας , δεν πληρούσε κανένα από αυτούς τους παράγοντες . Πρόσφατες μελέτες , καταδεικνύουν πως η ακτινοβολία , παίζει ένα σημαντικό ρόλο στους υποδοχείς της πρωτείνης κινάσης της τυροσίνης και ιδιαίτερα στην προς τα άνω ρύθμιση των MYC, KIT, και RET , καθώς και προς τα κάτω ρύθμιση του εξαρτώμενου από την κυκλίνη αναστολέα 2C της κινάσης . Οι κλινικές εκδηλώσεις του αγγειοσαρκώματος , εξαρτώνται κυρίως από την θέση ανάπτυξης του . Επιφανειακοί όγκοι , εμφανίζονται συχνά ως ταχέως αναπτυσσόμενες μάζες μαλακών ιστών . Αντιθέτως , εν τω βάθει εντοπιζόμενα αγγειοσαρκώματα , είναι εξαιρετικά δύσκολο να εντοπιστούν πρόωρα , παρά μόνο αφού εκδηλωθούν συμπτώματα λόγω της ασκούμενης πίεσης και / ή του πόνου . Εάν αφεθούν χωρίς θεραπεία , τα αγγειοσαρκώματα αναπτύσσονται τάχιστα – φθάνοντας τα 20 εκ . ή και μεγαλύτερα – με κίνδυνο να ραγούν και να προκληθεί δυνητικά μεγάλη αιμορραγία , όπως στην περίπτωση μας . Η συχνότητα εμφάνισης υποτροπών ή μεταστάσεων είναι μεγάλη και ως εκ τούτου απαιτείται μετεγχειρητικά η παρακολούθηση τους σε τακτά χρονικά διαστήματα με απεικονιστικές μεθόδους . Ο ασθενής της ανακοίνωσης μας , απεβίωσε 18 μήνες μετά την χειρουργική παρέμβαση , μετά την εμφάνιση πολλαπλών μεταστάσεων σε αμφότερους τους πνεύμονες. Αυτό επιβεβαιώνει την αντίληψη , ότι το αγγειοσάρκωμα είναι μία επιθετική κακοήθεια , η οποία έχει δυστυχώς πολύ άσχημη πρόγνωση . Η ανακοινωθείσα περίπτωση , υποστηρίζει την άποψη πολλών μελετών , πως όγκοι μεγαλύτεροι των 5 εκ . συνδέονται με την χειρότερη πρόγνωση . Οι απεικονιστικές εξετάσεις , στερούνται εξειδίκευσης αναφορικά με την διάγνωση του αγγειοσαρκώματος . Απαιτούνται επομένως συνδυαστικά , τόσο η αξονική τομογραφία , όσο και η μαγνητική και το PET Scan , προκειμένου να καθοριστεί η ανατομία του όγκου και η έκταση της διασποράς του . Η εξέταση του αγγειοσαρκώματος με αξονική τομογραφία , αποκαλύπτει τα παρακάτω 1) ωοειδείς μάζες μαλακών ιστών , με ή χωρίς λοβωτό περίγραμμα 2) ασαφή περιγράμματα με πυκνότητες κατώτερες εκείνων των μυών και 3) πιθανή παρουσία αιμορραγίας , νέκρωσης ή και επασβεστώσεις εντός της νεοπλασματικής μάζας . Η εξέταση του αγγειοσαρκώματος με μαγνητική τομογραφία , αποκαλύπτει τα παρακάτω 1) T1 weighted απεικονίσεις (T1WI) παράγουν ένα ανισότιμο χαμηλό σήμα 2) T2 weighted απεικονίσεις (T2WI) παράγουν εικόνες υψηλού σήματος . Πάντως ο χρυσός κανόνας για την διάγνωση του αγγειοσαρκώματος , είναι η ανοσοιστοχημεία . Λαμβανομένου υπ’ όψιν του γεγονότος , ότι η απεικονιστικά καθοδηγούμενη διαδερμική βιοψία προκαλεί ελάχιστη βλάβη , έχει χαμηλό κίνδυνο μεταφοράς κακοήθων κυττάρων δια της βελόνης και μπορεί να προσφέρει επαρκείς διαγνωστικές πληροφορίες , αποτελεί την πλέον αποτελεσματική μέθοδο ιστολογικής διάγνωσης για την συγκεκριμένη νόσο . Εξ’ αιτίας των ιδιαιτεροτήτων εντοπισμού , η οπισθοπεριτοναική προσπέλαση αποτελεί την πλέον προσφιλή οδό προσέγγισης της κακοήθειας αυτής . Εάν είναι ανέφικτη η προσέγγιση δια’ αυτής της οδού , ακολουθείται η διαπεριτοναική ως εναλλακτική λύση . Το οπισθοπεριτοναικό αγγειοσάρκωμα δέον όπως διαφοροδιαγνωστεί από τις παρακάτω νοσηρές καταστάσεις : 1) φαιοχρωμοκύττωμα ( οι περισσότεροι ασθενείς με τους όγκους αυτούς , έχουν ιστορικό ανθιστάμενης υψηλής πίεσης , ταχείες αλλαγές της αρτηριακής πίεσης και χαρακτηρίζονται από αυξημένη πυκνότητα , ενώ εμφανίζουν προδιάθεση για κυστική εκφύλιση και νέκρωση ) 2) οπισθοπεριτοναικό λίπωμα ( οι μάζες αυτές είναι κυρίως ωοειδείς ή λοβωτές μαλακές , με ομαλά περιγράμματα , περιβάλλονται από κάψα και έχουν ιδιαίτερα χαρακτηριστικά κατά τον υπερηχογραφικό έλεγχο 3) νευροβλάστωμα , το οποίο είναι συχνότερο στα παιδιά . Η χειρουργική εκτομή , αποτελεί την μέθοδο εκλογής για την αντιμετώπιση του αγγειοσαρκώματος . Πάντως , η μέση επιβίωση των ασθενών , που αντιμετωπίστηκαν μόνο χειρουργικά ανέρχεται στους 9 μήνες , με την 5ετή επιβίωση να κυμαίνεται γύρω στο 20% . Για τους ασθενείς που έλαβαν συμπληρωματικά ακτινοθεραπεία και χημειοθεραπεία , η μέση επιβίωση μπορεί να φθάσει και τους 36 μήνες , ενώ η 5ετής επιβίωση ανεβαίνει στο 45% . Κύριες αιτίες θανάτου , είναι η υποτροπή ( τοπική υποτροπή , συχνότητα 75% ) και απομακρυσμένες μεταστάσεις ( συχνότητα 34% ) . Η διεπιστημονική προσέγγιση των νεοπλασιών αυτών είναι απαραίτητη , αλλά παρά την πολυδιάστατη θεραπευτική αντιμετώπιση , η συχνότητα εμφάνισης υποτροπών είναι υψηλή ακόμη και στην περίπτωση μικρών και εντοπισμένων όγκων .
Συζήτηση
Angiosarcoma is an aggressive malignant tumor of endothelial cells arising from lymphatic or blood vessels, estimated to account for approximately 1% of all soft tissue sarcomas. The pathological manifestations of angiosarcoma vary according to the grade of malignancy of the different tumors.
For example, a low-grade angiosarcoma often presents as a small, solid focus/lesion with a small cell population and abundant transecting vessels. In contrast, the presentation of a high-grade angiosarcoma often includes hypercellularity, high mitotic activity, and atypical cells.
Angiosarcoma can occur in any part of the body, at all ages, although it is more frequently encountered in the elderly, with a mean age of 60-71 years. It is most commonly found in the skin (50% of cases), whereas retroperitoneal localization accounts for 10-15% of cases.
The etiology of angiosarcoma has not been elucidated. Risk factors are considered to be exposure to radiation or radiotherapy, chronic lymphedema, and exposure to chemicals such as vinyl chloride. The patient in our case did not meet any of these factors.
Recent studies demonstrate that radiation plays a significant role in tyrosine kinase receptors, particularly in the upregulation of MYC, KIT, and RET, as well as the downregulation of cyclin-dependent kinase inhibitor 2C.
The clinical manifestations of angiosarcoma depend mainly on its site of development. Superficial tumors often appear as rapidly growing soft tissue masses. In contrast, deeply located angiosarcomas are extremely difficult to identify early, except after symptoms develop due to pressure and/or pain.
If left untreated, angiosarcomas grow rapidly, reaching 20 cm or even larger, with a risk of rupture and potentially massive hemorrhage, as in our case. The frequency of recurrence or metastasis is high, and therefore postoperative follow-up at regular intervals with imaging methods is required.
The patient of our report died 18 months after surgical intervention, following the appearance of multiple metastases in both lungs. This confirms the concept that angiosarcoma is an aggressive malignancy with, unfortunately, a very poor prognosis.
The reported case supports the view of many studies that tumors larger than 5 cm are associated with a worse prognosis. Imaging examinations lack specificity for the diagnosis of angiosarcoma. Therefore, combined use of CT, MRI, and PET scan is required to determine the anatomy of the tumor and the extent of its spread.
CT examination of angiosarcoma reveals the following: 1) ovoid soft tissue masses, with or without a lobulated contour; 2) indistinct contours with densities lower than those of muscle; and 3) possible presence of hemorrhage, necrosis, or calcifications within the neoplastic mass.
MRI examination of angiosarcoma reveals the following: 1) T1-weighted images (T1WI) produce an inhomogeneous low signal; 2) T2-weighted images (T2WI) produce high-signal images. Nevertheless, the gold standard for the diagnosis of angiosarcoma is immunohistochemistry.
Considering that image-guided percutaneous biopsy causes minimal damage, carries a low risk of malignant cell seeding through the needle, and can provide sufficient diagnostic information, it constitutes the most effective method of histological diagnosis for this disease.
Due to the particularities of its location, the retroperitoneal approach is the most preferred route for accessing this malignancy. If approach via this route is not feasible, the transperitoneal approach is followed as an alternative. Retroperitoneal angiosarcoma should be distinguished from the following pathological conditions: 1) pheochromocytoma (most patients with these tumors have a history of resistant hypertension, rapid blood pressure fluctuations, and are characterized by increased density, with a tendency for cystic degeneration and necrosis); 2) retroperitoneal lipoma (these masses are mainly ovoid or lobulated, soft, with smooth contours, surrounded by a capsule, and have distinctive features on ultrasound examination); 3) neuroblastoma, which is more common in children.
Surgical excision is the treatment of choice for angiosarcoma. However, the median survival of patients treated with surgery alone is 9 months, with 5-year survival around 20%. For patients who received adjuvant radiotherapy and chemotherapy, median survival can reach 36 months, while 5-year survival rises to 45%.
The main causes of death are recurrence (local recurrence, incidence 75%) and distant metastases (incidence 34%). A multidisciplinary approach to these neoplasms is essential, but despite multimodal therapeutic management, the recurrence rate is high even in the case of small and localized tumors.
In conclusion, angiosarcoma is a rare, rapidly progressive, and highly aggressive tumor with a very poor prognosis, which can occur at any site in the body. Early diagnosis of retroperitoneal tumors is particularly difficult.
A combination of clinical examination and imaging studies (ultrasound, CT scan, MRI, and PET scan) is required in order to draw safe conclusions about the nature of these retroperitoneal tumors. Percutaneous biopsy is extremely important, as it may contribute to early diagnosis.
In order to achieve prolongation of survival in these patients, timely surgical excision of the neoplasm combined with targeted radiotherapy and chemotherapy is required.
Βασικά Σημεία Μάθησης
- Retroperitoneal angiosarcoma is exceedingly rare with poor prognosis (median survival 12-16 months)
- IHC confirms endothelial origin: CD31+, CD34+, Factor VIII+
- Complete surgical resection with negative margins is the most important prognostic factor
- Paclitaxel-based chemotherapy and radiation are adjuvant options
- High recurrence rate necessitates close surveillance
Primary retroperitoneal angiosarcomas are extremely rare, constituting a small fraction of retroperitoneal sarcomas, which themselves occur with a frequency of 0.0027%.
Συνδεθείτε για να σχολιάσετε
Φόρτωση...